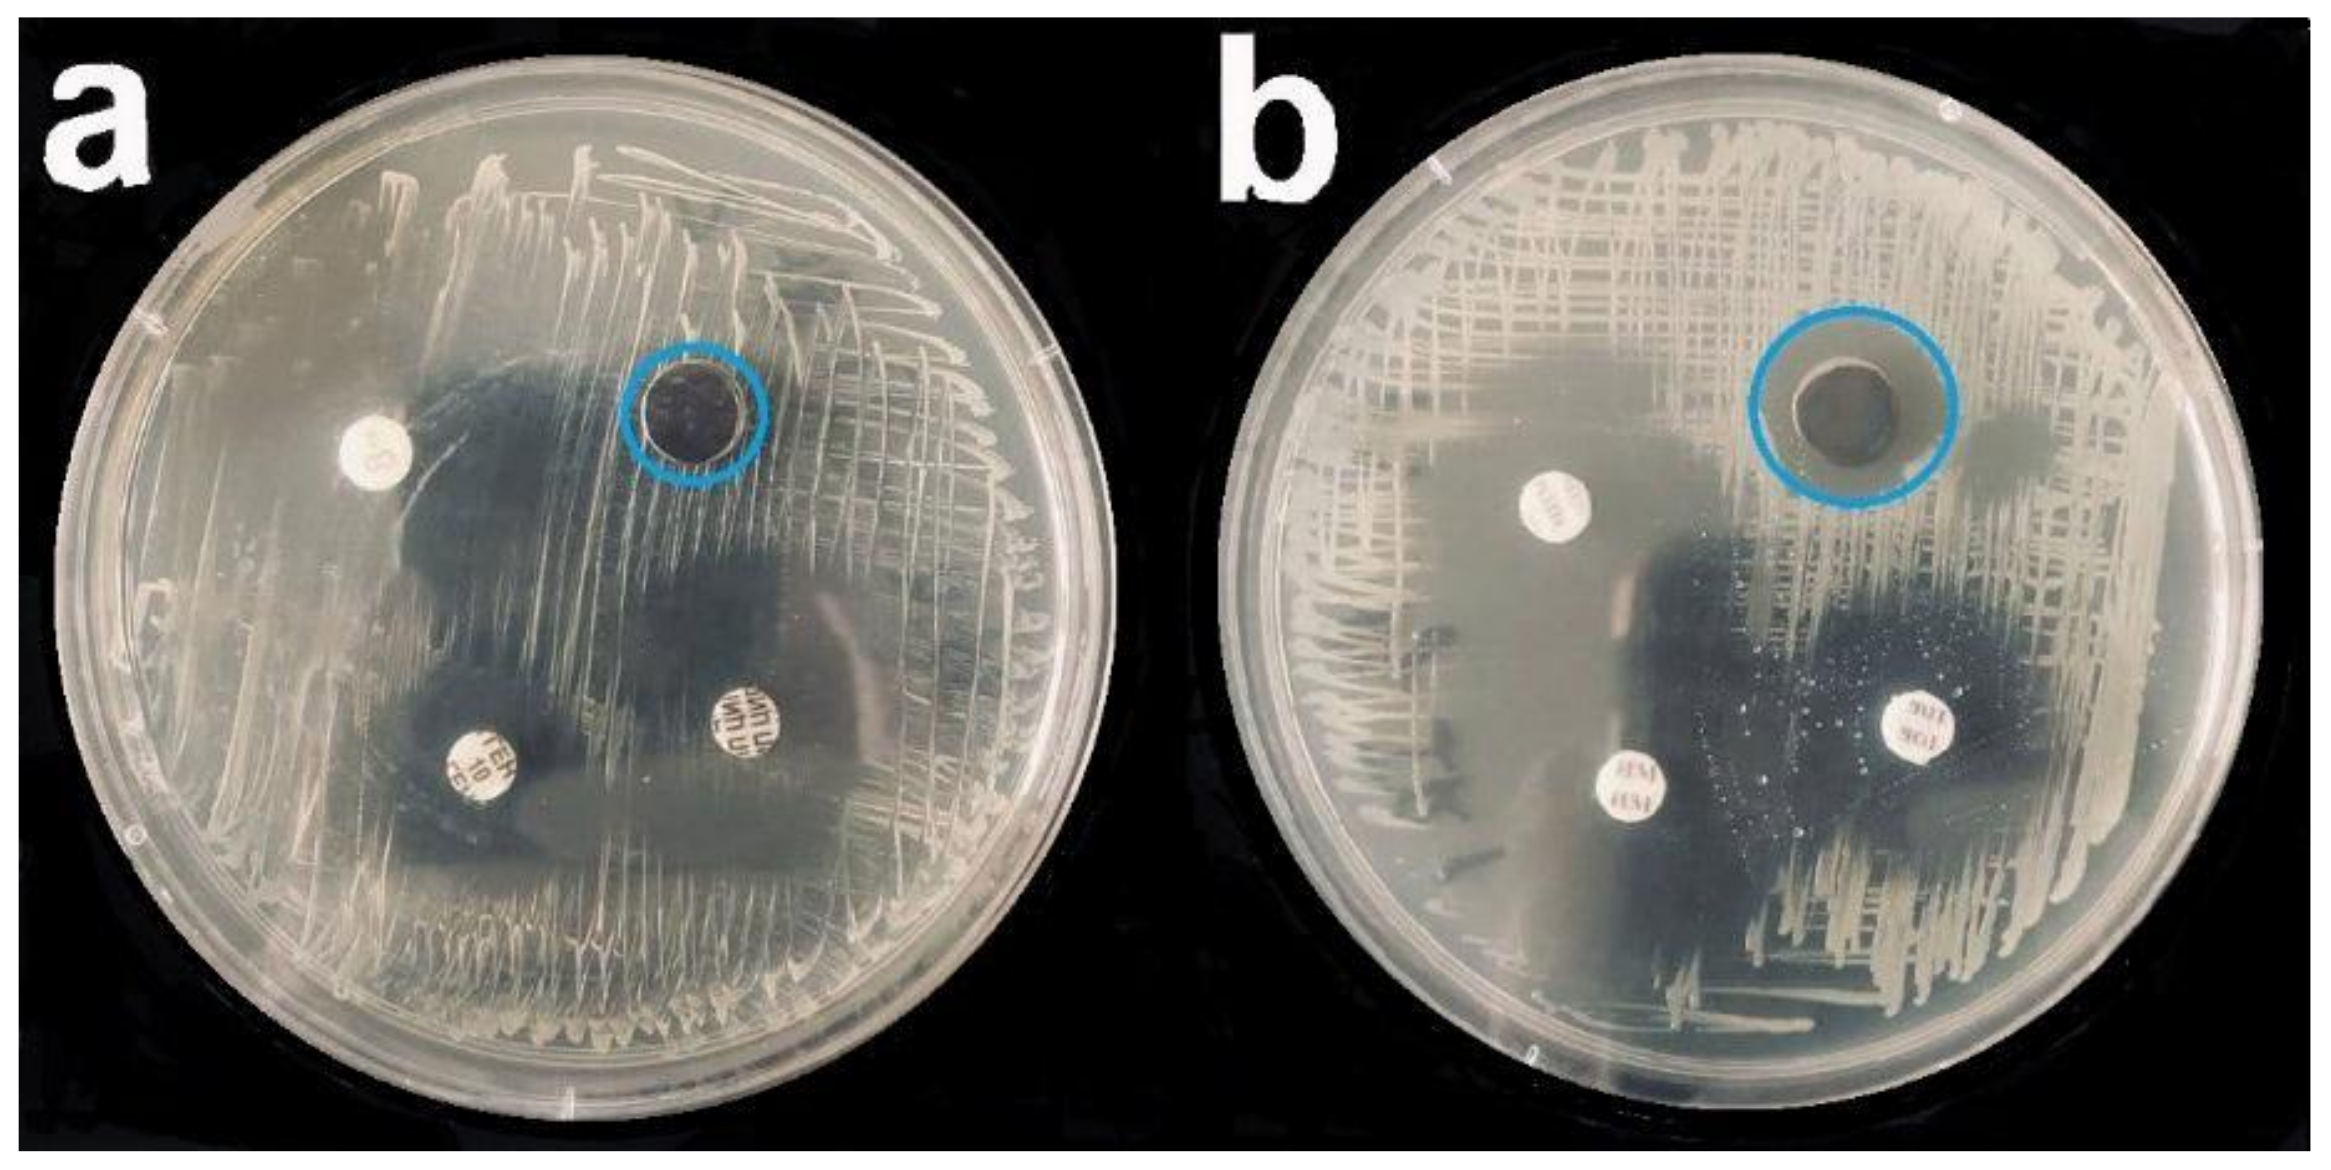

Noble Metals for Modern Implant Materials: MOCVD of Film Structures and Cytotoxical, Antibacterial, and Histological Studies
Abstract
:1. Introduction
- -
- composition, microstructure, and surface characteristics;
- -
- cytotoxic properties in the culture of donor peripherical blood mononuclear cells using an XTT test;
- -
- cytokine composition of the culture medium during cocultivation of mononuclear blood cells with the studied samples;
- -
- antibacterial properties in bacterial cultures S. epidermidis, S. aureus, Str. pyogenes, P. aeruginosa, and Ent. faecium via a disc diffusion method;
- -
- evaluation of in vivo biocompatibility and histological examinations.
2. Materials and Methods
2.1. Deposition of Ir, Pt, and IrPt Metal Coatings and Au and Ag Nanoparticles
2.2. X-ray Diffraction Analysis
2.3. Scanning Electron Microscopy
2.4. X-ray Photoelectron Spectroscopy
2.5. Atomic Emission Spectroscopy
2.6. Electrochemical Characteristics of Ir and Pt Films
2.7. Biological Research
2.7.1. Preparation of the Experimental Samples
2.7.2. Preparation of the Mononuclear Blood Cells
2.7.3. Determination of Cytotoxicity of Samples by the XTT Test
2.7.4. Investigation of the Cytokine Composition of the PBMC Culture Medium
2.7.5. Studies of the Antibacterial Activity of Samples
2.7.6. Statistical Analysis
2.7.7. Valuation of Sample Biocompatibility in Histological Studies
3. Results and Discussion
3.1. Characterization of Ir, Pt, and PtIr Coatings
3.1.1. Iridium Coatings
3.1.2. Platinum Coatings
3.1.3. Bimetallic Coatings
3.1.4. Corrosion Resistance Test of Coatings
3.2. Characterization of Noble-Metal Coatings Modified by Au and Ag Nanoparticles
3.3. Biological Studies
3.3.1. Cytotoxic Activity
3.3.2. Cytokine Release by PBMC
3.3.3. Studies of Antibacterial Properties
3.3.4. Histological Studies
Structural Features of the Fibrous Capsule
Average Thickness of the Fibrous Capsule
4. Conclusions
Supplementary Materials
Author Contributions
Funding
Institutional Review Board Statement
Informed Consent Statement
Data Availability Statement
Conflicts of Interest
References
- Williams, D.F. On the mechanisms of biocompatibility. Biomaterials 2008, 29, 2941–2953. [Google Scholar] [CrossRef] [PubMed]
- Basova, T.V.; Vikulova, E.S.; Dorovskikh, S.I.; Hassan, A.; Morozova, N.B. The use of noble metal coatings and nanoparticles for the modification of medical implant materials. Mater. Des. 2021, 204, 109672. [Google Scholar] [CrossRef]
- Albrektsson, T.; Chrcanovic, B.; Östman, P.-O.; Sennerby, L. Initial and long-term crestal bone responses to modern dental implants. Periodontology 2000 2017, 73, 41–50. [Google Scholar] [CrossRef] [PubMed]
- Hu, C.; Ashok, D.; Nisbet, D.R.; Gautam, V. Bioinspired surface modification of orthopedic implants for bone tissue engineering. Biomaterials 2019, 219, 119366. [Google Scholar] [CrossRef]
- Steigenga, J.T.; Al-Shammari, K.F.; Nociti, F.H.; Misch, C.E.; Wang, H.-L. Dental Implant Design and Its Relationship to Long-Term Implant Success. Implant Dent. 2003, 12, 306–317. [Google Scholar] [CrossRef]
- Geetha, M.; Singh, A.K.; Asokamani, R.; Gogia, A.K. Ti based biomaterials, the ultimate choice for orthopaedic implants—A review. Prog. Mater. Sci. 2009, 54, 397–425. [Google Scholar] [CrossRef]
- Niinomi, M.; Nakai, M.; Hieda, J. Development of new metallic alloys for biomedical applications. Acta Biomater. 2012, 8, 3888–3903. [Google Scholar] [CrossRef]
- Wang, X.; Xu, S.; Zhou, S.; Xu, W.; Leary, M.; Choong, P.; Qian, M.; Brandt, M.; Xie, Y.M. Topological design and additive manufacturing of porous metals for bone scaffolds and orthopaedic implants: A review. Biomaterials 2016, 83, 127–141. [Google Scholar] [CrossRef]
- Chen, Q.; Thouas, G.A. Metallic implant biomaterials. Mater. Sci. Eng. R Rep. 2015, 87, 1–57. [Google Scholar] [CrossRef]
- Hallab, N.; Merritt, K.; Jacobs, J.J. Metal sensitivity in patients with orthopaedic implants. J. Bone Joint Surg. 2001, 83, 428–436. [Google Scholar] [CrossRef]
- Okazaki, Y.; Gotoh, E. Comparison of metal release from various metallic biomaterials in vitro. Biomaterials 2005, 26, 11–21. [Google Scholar] [CrossRef]
- Shabalovskaya, S.; Anderegg, J.; Van Humbeeck, J. Critical overview of Nitinol surfaces and their modifications for medical applications. Acta Biomater. 2008, 4, 447–467. [Google Scholar] [CrossRef]
- Mahmood, B.; Hammert, W.C. Metal implant allergy. J. Hand Surg. 2015, 40, 831–834. [Google Scholar] [CrossRef]
- Goldenberg, Y.; Tee, J.W.; Salinas-La Rosa, C.M.; Murphy, M. Spinal metallosis: A systematic review. Eur. Spine J. 2016, 25, 1467–1473. [Google Scholar] [CrossRef]
- Abuayyash, A.; Ziegler, N.; Gessmann, J.; Sengstock, C.; Schildhauer, T.A.; Ludwig, A.; Köller, M. Antibacterial Efficacy of Sacrifical Anode Thin Films Combining Silver with Platinum Group Elements within a Bacteria-Containing Human Plasma Clot. Adv. Eng. Mater. 2018, 20, 1700493. [Google Scholar] [CrossRef]
- Aderibigbe, B.A. Metal-Based Nanoparticles for the Treatment of Infectious Diseases. Molecules 2017, 22, 1370. [Google Scholar] [CrossRef]
- Sengstock, C.; Lopian, M.; Motemani, Y.; Borgmann, A.; Khare, C.; Buenconsejo, P.J.S.; Schildhauer, T.A.; Ludwig, A.; Köller, M. Structure-related antibacterial activity of a titanium nanostructured surface fabricated by glancing angle sputter deposition. Nanotechnology 2014, 25, 195101. [Google Scholar] [CrossRef]
- Köller, M.; Bellova, P.; Javid, S.M.; Motemani, Y.; Khare, C.; Sengstock, C.; Tschulik, K.; Schildhauer, T.A.; Ludwig, A. Antibacterial activity of microstructured sacrificial anode thin films by combination of silver with platinum group elements (platinum, palladium, iridium). Mater. Sci. Eng. C 2017, 74, 536–541. [Google Scholar] [CrossRef]
- Li, B.; Webster, T.J. Bacteria antibiotic resistance: New challenges and opportunities for implant-associated orthopedic infections. J. Orthop. Res. 2018, 36, 22–32. [Google Scholar] [CrossRef] [Green Version]
- Abdalla, S.S.I.; Katas, H.; Azmi, F.; Busra, M.F.M. Antibacterial and Anti-Biofilm Biosynthesised Silver and Gold Nanoparticles for Medical Applications: Mechanism of Action, Toxicity and Current Status. Curr. Drug Deliv. 2020, 17, 88–100. [Google Scholar] [CrossRef]
- Qing, Y.; Cheng, L.; Li, R.; Liu, G.; Zhang, Y.; Tang, X.; Wang, J.; Liu, H.; Qin, Y. Potential antibacterial mechanism of silver nanoparticles and the optimization of orthopedic implants by advanced modification technologies. Int. J. Nanomed. 2018, 13, 3311–3327. [Google Scholar] [CrossRef] [Green Version]
- Jyoti, K.; Baunthiyal, M.; Singh, A. Characterization of silver nanoparticles synthesized using Urtica dioica Linn. leaves and their synergistic effects with antibiotics. J. Radiat. Res. Appl. Sci. 2016, 9, 217–227. [Google Scholar] [CrossRef] [Green Version]
- Xu, N.; Cheng, H.; Xu, J.; Li, F.; Gao, B.; Li, Z.; Gao, C.; Huo, K.; Fu, J.; Xiong, W. Silver-loaded nanotubular structures enhanced bactericidal efficiency of antibiotics with synergistic effect in vitro and in vivo. Int. J. Nanomed. 2017, 12, 731–743. [Google Scholar] [CrossRef] [Green Version]
- Johnston, H.J.; Hutchison, G.; Christensen, F.M.; Peters, S.; Hankin, S.; Stone, V. A review of the in vivo and in vitro toxicity of silver and gold particulates: Particle attributes and biological mechanisms responsible for the observed toxicity. Crit. Rev. Toxicol. 2010, 40, 328–346. [Google Scholar] [CrossRef]
- Karakovskaya, K.I.; Dorovskikh, S.I.; Vikulova, E.S.; Ilyin, I.Y.; Zherikova, K.V.; Basova, T.V.; Morozova, N.B. Volatile Iridium and Platinum MOCVD Precursors: Chemistry, Thermal Properties, Materials and Prospects for Their Application in Medicine. Coatings 2021, 11, 78. [Google Scholar] [CrossRef]
- Lozanov, V.V.; Il’in, I.Y.; Morozova, N.B.; Trubin, S.V.; Baklanova, N.I. Chemical Vapor Deposition of an Iridium Phase on Hafnium Carbide and Tantalum Carbide. Russ. J. Inorg. Chem. 2020, 65, 1781–1788. [Google Scholar] [CrossRef]
- Bespyatov, M.A.; Kuzin, T.M.; Naumov, V.N.; Vikulova, E.S.; Ilyin, I.Y.; Morozova, N.B.; Gelfond, N. V Low-temperature heat capacity of Ir(C5H7O2)(C8H12). J. Chem. Thermodyn. 2016, 99, 70–74. [Google Scholar] [CrossRef]
- Thurier, C.; Doppelt, P. Platinum OMCVD processes and precursor chemistry. Coord. Chem. Rev. 2008, 252, 155–169. [Google Scholar] [CrossRef]
- Bespyatov, M.A.; Kuzin, T.M.; Naumov, V.N.; Zharkova, G.I.; Gelfond, N.V.; Dorovskikh, S.I.; Morozova, N.B. Low-temperature thermodynamic properties of Pt(C5H7O2)2. J. Therm. Anal. Calorim. 2016, 123, 899–903. [Google Scholar] [CrossRef]
- Basova, T.V.; Hassan, A.; Morozova, N.B. Chemistry of gold(I, III) complexes with organic ligands as potential MOCVD precursors for fabrication of thin metallic films and nanoparticles. Coord. Chem. Rev. 2019, 380, 58–82. [Google Scholar] [CrossRef] [Green Version]
- Gelfond, N.V.; Krisyk, V.V.; Dorovskikh, S.I.; Kal’Nyi, D.B.; Maksimovskii, E.A.; Shubin, Y.V.; Trubin, S.V.; Morozova, N.B. Structure of platinum coatings obtained by chemical vapor deposition. J. Struct. Chem. 2015, 56, 1215–1219. [Google Scholar] [CrossRef]
- Nikolaeva, N.S.; Klyamer, D.D.; Zharkov, S.M.; Tsygankova, A.R.; Sukhikh, A.S.; Morozova, N.B.; Basova, T.V. Heterostructures based on Pd–Au nanoparticles and cobalt phthalocyanine for hydrogen chemiresistive sensors. Int. J. Hydrogen Energy 2021, 46, 19682–19692. [Google Scholar] [CrossRef]
- Semyannikov, P.P.; Moroz, B.L.; Trubin, S.V.; Zharkova, G.I.; Pyryaev, P.A.; Smirnov, M.Y.; Bukhtiyarov, V.I. Chemical vapor infiltration method for deposition of gold nanoparticles on porous alumina supports. J. Struct. Chem. 2006, 47, 458–464. [Google Scholar] [CrossRef]
- Powder Diffraction File; International Centre for Diffraction Data: Newtown Square, PA, USA. 2010. Available online: https://www.icdd.com/pdfsearch/ (accessed on 15 July 2021).
- Kraus, W.; Nolze, G. POWDER CELL—A program for the representation and manipulation of crystal structures and calculation of the resulting X-ray powder patterns. J. Appl. Crystallogr. 1996, 29, 301–303. [Google Scholar] [CrossRef]
- Pfeifer, V.; Jones, T.E.; Velasco Vélez, J.J.; Massué, C.; Greiner, M.T.; Arrigo, R.; Teschner, D.; Girgsdies, F.; Scherzer, M.; Allan, J.; et al. The electronic structure of iridium oxide electrodes active in water splitting. Phys. Chem. Chem. Phys. 2016, 18, 2292–2296. [Google Scholar] [CrossRef] [Green Version]
- Dorovskikh, S.I.; Vikulova, E.S.; Kal’nyi, D.B.; Shubin, Y.V.; Asanov, I.P.; Maximovskiy, E.A.; Gutakovskii, A.K.; Morozova, N.B.; Basova, T.V. Bimetallic Pt,Ir-containing coatings formed by MOCVD for medical applications. J. Mater. Sci. Mater. Med. 2019, 30, 69. [Google Scholar] [CrossRef]
- Wu, W.; Liu, J.; Zhang, Y.; Wang, X. Electrochemical characteristics of iridium coating by double glow plasma discharge process on titanium alloy substrates. Surf. Eng. 2019, 35, 954–961. [Google Scholar] [CrossRef]
- Albers, C.E.; Hofstetter, W.; Siebenrock, K.A.; Landmann, R.; Klenke, F.M. In vitro cytotoxicity of silver nanoparticles on osteoblasts and osteoclasts at antibacterial concentrations. Nanotoxicology 2013, 7, 30–36. [Google Scholar] [CrossRef]
- Kim, S.; Choi, J.E.; Choi, J.; Chung, K.-H.; Park, K.; Yi, J.; Ryu, D.-Y. Oxidative stress-dependent toxicity of silver nanoparticles in human hepatoma cells. Toxicol. Vitr. 2009, 23, 1076–1084. [Google Scholar] [CrossRef]
- Greulich, C.; Braun, D.; Peetsch, A.; Diendorf, J.; Siebers, B.; Epple, M.; Köller, M. The toxic effect of silver ions and silver nanoparticles towards bacteria and human cells occurs in the same concentration range. RSC Adv. 2012, 2, 6981–6987. [Google Scholar] [CrossRef]
- Vanýsek, P. Electrochemical Series. In CRC Handbook of Chemistry and Physics, 83th ed.; Lide, D.R., Ed.; CRC Press: Boca Raton, FL, USA, 2002; pp. 8-1–8-13. [Google Scholar]
- Shareena Dasari, T.P.; Zhang, Y.; Yu, H. Antibacterial Activity and Cytotoxicity of Gold (I) and (III) Ions and Gold Nanoparticles. Biochem. Pharmacol. 2015, 4, 199. [Google Scholar] [CrossRef] [Green Version]
- Khlebtsov, N.; Dykman, L. Biodistribution and toxicity of engineered gold nanoparticles: A review of in vitro and in vivo studies. Chem. Soc. Rev. 2011, 40, 1647–1671. [Google Scholar] [CrossRef]
- Gu, X.; Xu, Z.; Gu, L.; Xu, H.; Han, F.; Chen, B.; Pan, X. Preparation and antibacterial properties of gold nanoparticles: A review. Environ. Chem. Lett. 2020, 19, 167–187. [Google Scholar] [CrossRef]
- Mironava, T.; Hadjiargyrou, M.; Simon, M.; Jurukovski, V.; Rafailovich, M.H. Gold nanoparticles cellular toxicity and recovery: Effect of size, concentration and exposure time. Nanotoxicology 2010, 4, 120–137. [Google Scholar] [CrossRef]
- Mateo, D.; Morales, P.; Ávalos, A.; Haza, A.I. Comparative cytotoxicity evaluation of different size gold nanoparticles in human dermal fibroblasts. J. Exp. Nanosci. 2015, 10, 1401–1417. [Google Scholar] [CrossRef] [Green Version]
- Paino, I.M.M.; Marangoni, V.S.; de Oliveira, R.D.C.S.; Antunes, L.M.G.; Zucolotto, V. Cyto and genotoxicity of gold nanoparticles in human hepatocellular carcinoma and peripheral blood mononuclear cells. Toxicol. Lett. 2012, 215, 119–125. [Google Scholar] [CrossRef]
- Li, T.; Albee, B.; Alemayehu, M.; Diaz, R.; Ingham, L.; Kamal, S.; Rodriguez, M.; Bishnoi, S.W. Comparative toxicity study of Ag, Au, and Ag–Au bimetallic nanoparticles on Daphnia magna. Anal. Bioanal. Chem. 2010, 398, 689–700. [Google Scholar] [CrossRef]
- Formaggio, D.M.D.; de Oliveira Neto, X.A.; Rodrigues, L.D.A.; de Andrade, V.M.; Nunes, B.C.; Lopes-Ferreira, M.; Ferreira, F.G.; Wachesk, C.C.; Camargo, E.R.; Conceição, K.; et al. In vivo toxicity and antimicrobial activity of AuPt bimetallic nanoparticles. J. Nanopart. Res. 2019, 21, 244. [Google Scholar] [CrossRef]
- Cachinho, S.C.P.; Pu, F.; Hunt, J.A. Cytokine secretion from human peripheral blood mononuclear cells cultured in vitro with metal particles. J. Biomed. Mater. Res. Part A 2013, 101, 1201–1209. [Google Scholar] [CrossRef]
- Navarro, M.; Fraile, G.; Velásquez, M.; González, E.; Escalona, J.; Ilanjian, R.; Abad, M.J.; Taylor, P. Effect of a gold-chloroquine complex on inflammation-related leukocyte functions and cell viability. Comparison with auranofin. Arzneimittelforschung 2006, 56, 826–833. [Google Scholar] [CrossRef]
- De Lima, J.M.; Ferreira, E.P.; Bonan, R.F.; Silva-Teixeira, D.N.; Goulart, L.R.; de Souza, J.R.; de Medeiros, E.S.; Bonan, P.R.F.; Castellano, L.R.C. Cytokine Regulation from human peripheral blood leukocytes cultured in vitro with silver doped bioactive glasses microparticles. Biomed Res. Int. 2019, 2019, 3210530. [Google Scholar] [CrossRef] [PubMed] [Green Version]
- Vishwakarma, A.; Bhise, N.S.; Evangelista, M.B.; Rouwkema, J.; Dokmeci, M.R.; Ghaemmaghami, A.M.; Vrana, N.E.; Khademhosseini, A. Engineering Immunomodulatory Biomaterials to Tune the Inflammatory Response. Trends Biotechnol. 2016, 34, 470–482. [Google Scholar] [CrossRef] [PubMed]
- Ramstedt, M.; Ekstrand-Hammarström, B.; Shchukarev, A.V.; Bucht, A.; Österlund, L.; Welch, M.; Huck, W.T.S. Bacterial and mammalian cell response to poly(3-sulfopropyl methacrylate) brushes loaded with silver halide salts. Biomaterials 2009, 30, 1524–1531. [Google Scholar] [CrossRef] [PubMed]
- Feng, Q.L.; Wu, J.; Chen, G.Q.; Cui, F.Z.; Kim, T.N.; Kim, J.O. A mechanistic study of the antibacterial effect of silver ions on Escherichia coli and Staphylococcus aureus. J. Biomed. Mater. Res. 2000, 52, 662–668. [Google Scholar] [CrossRef]
- Alt, V.; Bechert, T.; Steinrücke, P.; Wagener, M.; Seidel, P.; Dingeldein, E.; Domann, E.; Schnettler, R. An in vitro assessment of the antibacterial properties and cytotoxicity of nanoparticulate silver bone cement. Biomaterials 2004, 25, 4383–4391. [Google Scholar] [CrossRef]
- Suska, F.; Svensson, S.; Johansson, A.; Emanuelsson, L.; Karlholm, H.; Ohrlander, M.; Thomsen, P. In vivo evaluation of noble metal coatings. J. Biomed. Mater. Res. Part B Appl. Biomater. 2010, 92, 86–94. [Google Scholar] [CrossRef]
- Rodrigues, D.C.; Urban, R.M.; Jacobs, J.J.; Gilbert, J.L. In vivo severe corrosion and hydrogen embrittlement of retrieved modular body titanium alloy hip-implants. J. Biomed. Mater. Res. Part B Appl. Biomater. 2009, 88, 206–219. [Google Scholar] [CrossRef] [Green Version]
- Swaminathan, V.; Gilbert, J.L. Fretting corrosion of CoCrMo and Ti6Al4V interfaces. Biomaterials 2012, 33, 5487–5503. [Google Scholar] [CrossRef]
- Dalrymple, A.N.; Huynh, M.; Nayagam, B.A.; Lee, C.D.; Weiland, G.R.; Petrossians, A.; John, J.; Fallon, J.B.; Shepherd, R.K. Electrochemical and biological characterization of thin-film platinum-iridium alloy electrode coatings: A chronic in vivo study. J. Neural Eng. 2020, 17, 036012. [Google Scholar] [CrossRef]
- Muñoz, R.; Leija, L.; Alvarez, J.; Reyes, J.L.; Flores, J.; Hedz, P.-R.; Minor, A.; Sierra, G. Evaluation of electrical impedance of Pt–Ir epimysial electrodes under implantation in muscles. Sens. Actuators A Phys. 2002, 101, 117–122. [Google Scholar] [CrossRef]
- Høl, P.J.; Kristoffersen, E.K.; Gjerdet, N.R.; Pellowe, A.S. Novel Nanoparticulate and Ionic Titanium Antigens for Hypersensitivity Testing. Int. J. Mol. Sci. 2018, 19, 1101. [Google Scholar] [CrossRef] [Green Version]
- Dodo, C.G.; Meirelles, L.; Aviles-Reyes, A.; Ruiz, K.G.S.; Abranches, J.; Cury, A.A.D.B. Pro-inflammatory Analysis of Macrophages in Contact with Titanium Particles and Porphyromonas gingivalis. Braz. Dent. J. 2017, 28, 428–434. [Google Scholar] [CrossRef] [Green Version]

| Group of Samples | P. aeruginosa | S. aureus | S. epidermidis | Str. pyogenes | Ent. gaecium |
|---|---|---|---|---|---|
| Ti-alloy | 10 | 10 | 10 | 10 | 10 |
| Ag | 19.9 ± 0.5 | 16.4 ± 0.5 | 20.3 ± 0.5 | 13.7 ± 0.3 | 16.0 ± 0.4 |
| Ag/Pt | 18.3 ± 0.9 | 16.0 ± 0.4 | 20.0 ± 0.3 | 14.0 ± 0.4 | 16.3 ± 0.6 |
| Ag/Ir | 20.1 ± 0.4 | 16.7 ± 0.4 | 20.0 ± 0.4 | 13.3 ± 0.5 | 16.0 ± 0.4 |
| Ag/PtIr | 19.5 ± 0.2 | 16.0 ± 0.3 | 20.3 ± 0.6 | 14.0 ± 0.5 | 16.3 ± 0.4 |
Publisher’s Note: MDPI stays neutral with regard to jurisdictional claims in published maps and institutional affiliations. |
© 2021 by the authors. Licensee MDPI, Basel, Switzerland. This article is an open access article distributed under the terms and conditions of the Creative Commons Attribution (CC BY) license (https://creativecommons.org/licenses/by/4.0/).
Share and Cite
Dorovskikh, S.I.; Vikulova, E.S.; Chepeleva, E.V.; Vasilieva, M.B.; Nasimov, D.A.; Maksimovskii, E.A.; Tsygankova, A.R.; Basova, T.V.; Sergeevichev, D.S.; Morozova, N.B. Noble Metals for Modern Implant Materials: MOCVD of Film Structures and Cytotoxical, Antibacterial, and Histological Studies. Biomedicines 2021, 9, 851. https://doi.org/10.3390/biomedicines9080851
Dorovskikh SI, Vikulova ES, Chepeleva EV, Vasilieva MB, Nasimov DA, Maksimovskii EA, Tsygankova AR, Basova TV, Sergeevichev DS, Morozova NB. Noble Metals for Modern Implant Materials: MOCVD of Film Structures and Cytotoxical, Antibacterial, and Histological Studies. Biomedicines. 2021; 9(8):851. https://doi.org/10.3390/biomedicines9080851
Chicago/Turabian StyleDorovskikh, Svetlana I., Evgeniia S. Vikulova, Elena V. Chepeleva, Maria B. Vasilieva, Dmitriy A. Nasimov, Eugene A. Maksimovskii, Alphiya R. Tsygankova, Tamara V. Basova, David S. Sergeevichev, and Natalya B. Morozova. 2021. "Noble Metals for Modern Implant Materials: MOCVD of Film Structures and Cytotoxical, Antibacterial, and Histological Studies" Biomedicines 9, no. 8: 851. https://doi.org/10.3390/biomedicines9080851
APA StyleDorovskikh, S. I., Vikulova, E. S., Chepeleva, E. V., Vasilieva, M. B., Nasimov, D. A., Maksimovskii, E. A., Tsygankova, A. R., Basova, T. V., Sergeevichev, D. S., & Morozova, N. B. (2021). Noble Metals for Modern Implant Materials: MOCVD of Film Structures and Cytotoxical, Antibacterial, and Histological Studies. Biomedicines, 9(8), 851. https://doi.org/10.3390/biomedicines9080851

